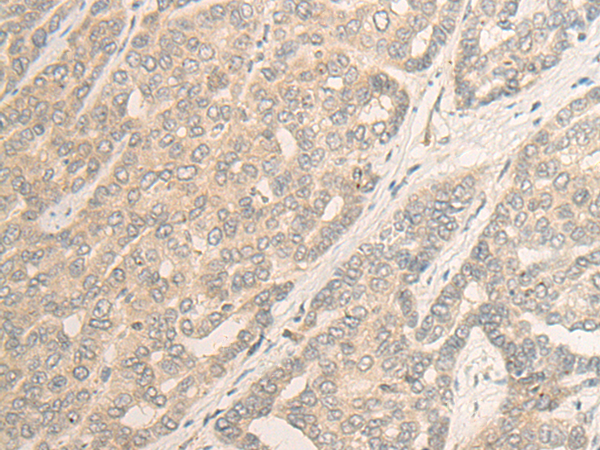

-
分类: 科研抗体货号: P09644别名: Nopp34; MKI67IP应用: WB,IHC反应种属: Human
-
分类: 科研抗体货号: P09645别名: 239FB; C11orf8应用: IHC反应种属: Human, Mouse, Rat
-
分类: 科研抗体货号: P09659别名: UIF应用: IHC反应种属: Human, Mouse, Rat
-
分类: 科研抗体货号: P09643别名:应用: IHC反应种属: Human, Mouse, Rat
-
分类: 科研抗体货号: P09658别名:应用: IHC反应种属: Human
-
分类: 科研抗体货号: P09642别名:应用: WB,IHC反应种属: Human
-
分类: 科研抗体货号: P09641别名:应用: WB,IHC反应种属: Human, Mouse
-
分类: 科研抗体货号: P09656别名: DIM1; DIMT1L; HUSSY5; HSA9761应用: WB,IHC反应种属: Human, Mouse
-
分类: 科研抗体货号: P09667别名: AC40; RPA5; TCS3; HLD11; RPA39; RPA40; RPAC1; RPC40应用: IHC反应种属: Human, Mouse
-
分类: 科研抗体货号: P09655别名: SDR19C1应用: WB,IHC反应种属: Human, Mouse

鄂公网安备42018502007531号
鄂公网安备42018502007531号

